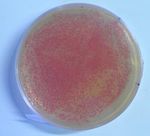
Создание биосенсоров на основе бактерий методами синтетической биологии - СУНЦ МГУ

Создание биосенсоров на основе бактерий методами синтетической биологии - СУНЦ МГУ
←
→
Транскрипция содержимого страницы
Если ваш браузер не отображает страницу правильно, пожалуйста, читайте содержимое страницы ниже
Создание биосенсоров на
основе бактерий методами
синтетической биологии
Выполнил ученик 10 Н класса СУНЦ МГУ Винников Р.С.
Научные руководители:
к.ф.м.н. Шайтан А.К., кафедра биоинженерии биологического факультета МГУ
к.б.н. Глухов Г.С., кафедра биоинженерии биологического факультета МГУВведение Влияние некоторых ТМ на организм
Металл Эффекты
В настоящее время уделяется все больше
внимания проблемам загрязнения окружающей 1. Zn Анемия, бессонница, ухудшение
среды. слуха
• Одним из важных факторов загрязнения 2. Pb Двигательные расстройства,
является загрязнение тяжелыми металлами поражение анализаторов
(ТМ) 3. Co Поражение сердца, ухудшение
• Для уменьшения вреда здоровью слуха
необходимо точно детектировать наличие ТМ 4. Cu Нарушение функций печени и
в среде.
почек, язва желудка
• Для этого мы разрабатываем биосенсор на
5. Hg Апатия, раздражимость,
основе бактерии, синтезирующий
флуоресцентный белок при наличии ТМ в ослабление памяти
среде. 6. Cd Ухудшение обоняния, снижение
• Для создания биосенсора мы используем аппетита, белок в моче, итай-итай
методы сравнительно нового направления в
биологии – синтетической биологии.
1Цели
Конечная общая цель проекта – создать биосенсор
на основе бактерии E. coli, который будет
синтезировать красный флуоресцентный белок
(RFP) в ответ на присутствие в среде тяжелых
металлов (кадмий, ртуть и т.д.)
Цель работы автора – разработать модель
экспрессии целевого белка в клетке.
Колония компетентной E. сoli,
трансформированная с
помощью вектора,
содержащего RFP (с сайта
parts.igem.org)
2Задачи
Работа состоит из двух частей: экспериментальной
и создания мат. модели.
• Задача мат. моделирования: создать koc - фактор формирования открытого комплекса
интерактивный график зависимости Np – число копий плазмиды
концентрации белка в клетке от времени на
Kp – константа диссоциации для связывания РНК-
основании информации из базы
данных bionumbers.hms.harvard.edu. полимеразы с ДНК
kt – фактор инициации трансляции
• Задача экспериментальной части: оценить рост kdm, kdp – факторы деградации мРНК и белка
экспрессии белка в клетке путём количественной
оценки экспрессии белка в бактерии
спектрофотометрическим методом.
3Методы
Для создания мат. модели (интерактивного графика)
используется язык программирования Python 3 с
такими библиотеками, как matplotlib, numpy и т.д.
Для лучшей визуализации, модель перенесена в
программу Jupyter Notebook.
Некоторые методы экспериментальной части:
Трансформация
Спектрофотометрия
№ пробы 1 2 3 4 5 6 7 8 9
Время 19 18,5 18 17,5 17 16,5 16 15,5 15
инкубирования
(ч)
4Результаты
5Выводы
• В результате работы была создана математическая модель экспрессии белка в клетке (показывающую
зависимость концентрации белка в клетке от времени).
• Модель была реализована в виде численного решения дифференциальных уравнений на языке Python 3. Для
модели был создан интерактивный интерфейс, позволяющий изменять параметры системы и осуществлять
визуализацию модели в виде графиков.
• Были проведены эксперименты и получена информация об экспрессии репортерного белка в реальной культуре
клеток E. coli, модифицированных плазмидой с геном красного флуоресцентного белка, в зависимости от
времени.
• Следует также отметить, что в будущем планируется уточнить модель путѐм учѐта особенностей роста культуры
клеток в ограниченном объѐме.
6Источники информации
• A.D. Endy. (2005). Foundations for engineering biology. Nature. 438, 449-453.
• Timothy S. Gardner, Charles R. Cantor, James J. Collins. (2000). Construction of a genetic toggle switch in
Escherichia coli. Nature. 403, 339-342.
• M. B. Elowitz, S. Leibler. (2000). A synthetic oscillatory network of transcriptional regulators. Nature. 403,
335-338.
• Powell K. (2018). How biologists are creating life-like cells from scratch. Nature. 563, 172-175.
• D. G. Gibson, G. A. Benders, C. Andrews-Pfannkoch, E. A. Denisova, H. Baden-Tillson, et. al. (2008). Complete
Chemical Synthesis, Assembly, and Cloning of a Mycoplasma genitalium Genome. Science. 319, 1215-1220.
• Lim J.W., Ha D., Lee J., Lee S.K. and Kim T. (2015) Review of Micro/Nanotechnologies for Microbial
Biosensors. Front. Bioeng. Biotechnol. 3:61. doi: 10.3389/fbioe.2015.00061.
• D’Souza S. F. (2001). Microbial biosensors. Biosens. Bioelectron. 16, 337–353.
• Lei Y., Chen W., Mulchandani A. (2006). Microbial biosensors. Anal. Chim. Acta. 568, 200–210.
• Su L., Jia W., Hou C., Lei Y. (2011). Microbial biosensors: a review. Biosens. Bioelectron. 26, 1788–1799.
• Gootenberg J.S., Abudayyeh O.O., Lee J.W. et al. (2017). Nucleic acid detection with CRISPR-Cas13a/C2c2.
Nature. 356, 438–442.
• Христофорова Н.К. (1985) Биоиндикация загрязнения морских вод тяжелыми металлами (докторская
диссертация).
7Спасибо за внимание! • Винников Ренат Сергеевич • renatvinnikov@gmail.com
Вы также можете почитать